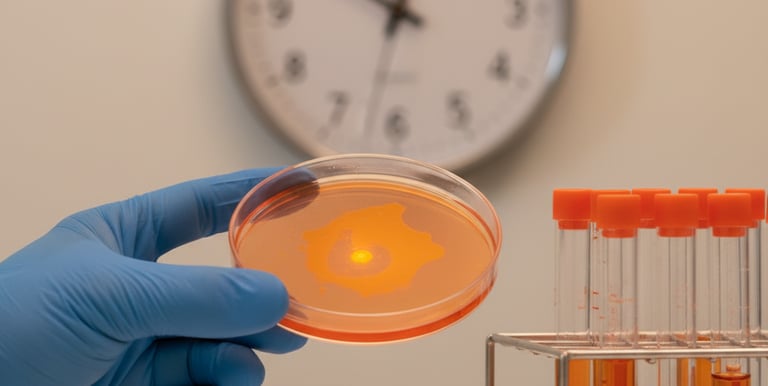
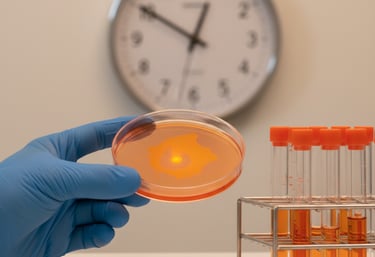

Exclusive discounts on medical supplies, contact us for special offers
Write your text here...
Your Trusted Medical Supply Partner
At Shams Nablus, we are dedicated to providing high-quality laboratory and medical supplies, ensuring customer satisfaction with our efficient service and competitive pricing.
Our customers are not just clients, they are our partners, we certify trust by warranting our products, Shams is your partner in success


Customer Satisfied
Items supplied
About Us

Quality Supplies
We offer a wide range of laboratory and medical supplies at competitive prices.
Customer Support
Our dedicated team is available
from 8:00 am to 12:00 am to assist you.
We are an independent company founded by two sisters in beloved Amman, Jordan, dedicated in supporting the healthcare sector with reliable, high-quality products. Specializing in medical and laboratory supplies. We serve laboratories, hospitals, clinics, and healthcare providers across the Hashemite Kingdom of Jordan. Built on trust, attention to detail, and a personal approach, we ensure every client receives the service they deserve—by offering flexible delivery, ensuring that urgent orders can reach our clients.
About
Your trusted source for laboratory essentials.


